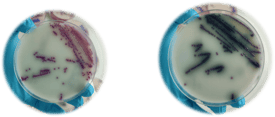
Salmonella Colonies in Culture Media

If the main serovars of Salmonella affecting specially birds (Salmonella Pullorum and Salmonella Gallinarum) have been eradicated from breeder flocks in many countries, Salmonella remains one of the main causes of foodborne illnesses with poultry products very often incriminated.
 Salmonella Enteritidis (SE), Salmonella Typhimurium (ST) and monophasic Typhimurium (mST) are among the most prevalent serovars reported after investigations by health authorities in the USA and the European Union.
Salmonella Enteritidis (SE), Salmonella Typhimurium (ST) and monophasic Typhimurium (mST) are among the most prevalent serovars reported after investigations by health authorities in the USA and the European Union.
Fortunately, vaccination of flocks is a suitable option to prevent these serious health risks and protect the livelihood of poultry farmers.
Rules for Successful Salmonella Vaccination
A few rules must be followed for a successful Live Salmonella vaccination.
Ensure Vaccine Viability
Since the vaccine contains live attenuated bacteria, it is essential to ensure that their viability has been respected, meaning the storage of vaccines under the right conditions and preventing usage of desinfectant water treatment during vaccination. This includes maintaining the cold chain from the manufacturer to the point of administration. Vaccines should be stored at temperatures recommended by the manufacturer, typically between 2°C and 8°C, and should never be frozen. Any deviation from these storage conditions can significantly reduce the effectiveness of the vaccine.
Since the vaccine contains live attenuated bacteria, it is essential to ensure that their viability has been respected, meaning the storage of vaccines under the right conditions and preventing usage of desinfectant water treatment during vaccination. This includes maintaining the cold chain from the manufacturer to the point of administration. Vaccines should be stored at temperatures recommended by the manufacturer, typically between 2°C and 8°C, and should never be frozen. Any deviation from these storage conditions can significantly reduce the effectiveness of the vaccine.
Antibiotic Treatment and Salmonella-Free Status
Then, the administration of live attenuated bacteria implies that birds should not receive any antibiotic treatment 3 days before and 3 days after vaccination and that the birds should be known as Salmonella-free since existing bacteria may jeopardize the colonization of the vaccinal bacteria. To verify the Salmonella-free status, regular testing and monitoring should be conducted. This can be done through environmental sampling or testing of individual birds. It's also crucial to maintain high standards of biosecurity to prevent the introduction of Salmonella into the flock.
Timing of Vaccination and Unison of Drinking
The water administration of the Live non-typhoidal Salmonella Enteriditis vaccines follows the classic rules for oral administration of vaccines (water deprivation for a short period prior to administration, correct calculation of estimated water intake and full consumption within a short amount of time). A key to success is to make sure that the birds will drink in unison the same amount of water within a short timeframe (2-4 hours). This ensures that all birds receive an adequate dose of the vaccine, maximizing the immunity of the flock.
The timing of vaccination is critical for its success. Vaccination should ideally be done during periods when the birds are less stressed, such as during the early morning or late evening when temperatures are cooler. Avoid vaccinating during extreme weather conditions or when the birds are undergoing other stressful events, such as transport or changes in diet.
Also, vaccinating healthy birds is key to obtain a proper immune response to vaccination. If the birds are not healthy, it is necessary to wait for the birds to recover before vaccinating them.
It is necessary to ensure that the pressure of the drinkers is correct to avoid water losses and inefficient vaccination.
Suspending Water Treatment
Although the Cevamune blue dye will inactivate chlorine-based cleaning agents and stabilize the water pH, it is recommended to suspend any water treatment (chlorine, peroxides or acidifiers) 24 hours prior to vaccination and resume it only 8 hours after vaccination. This precaution is necessary because the disinfectants in the water can kill the live vaccine bacteria before they are ingested by the birds, rendering the vaccination ineffective. Additionally, ensuring that birds have access to clean, fresh water after the vaccination period is crucial for their overall health and well-being.
Post-Vaccination Checking
After vaccination, it's important to monitor the flock for any signs of adverse reactions or illness. While live attenuated vaccines are generally safe, there can be occasional side effects such as mild respiratory symptoms or a slight decrease in feed intake. Monitoring includes observing the birds' behavior, appetite, and overall health. Any unusual signs should be reported to a veterinarian immediately. Regular sampling and testing should continue to ensure the ongoing effectiveness of the vaccination program and to detect any potential outbreaks of Salmonella.
Monitoring Vaccine Intake
 The presence of the vaccine dye on the tip of the tongue and mouth is a sure sign of proper vaccine intake. Observed on more than 90% of the birds, it means that the flock was properly vaccinated and will bring peace of mind to poultry farmers.
The presence of the vaccine dye on the tip of the tongue and mouth is a sure sign of proper vaccine intake. Observed on more than 90% of the birds, it means that the flock was properly vaccinated and will bring peace of mind to poultry farmers.
However, the viability of the vaccine in the drinking water should also be tested as the presence of the blue dye is not a proof by itself. This can be done by taking water samples at various points during the vaccination period and culturing them to ensure the presence of live vaccine bacteria.
Record Keeping
Maintaining accurate records of vaccination is essential for managing poultry health. This includes documenting the date of vaccination, the type of vaccine used, the batch number, and any observations made during and after vaccination. These records can help in tracking the effectiveness of the vaccination program and in making informed decisions about future vaccinations. They are also useful for regulatory compliance and for providing documentation in the event of a disease outbreak.
Integrating Vaccination with Overall Health Programs
Salmonella Vaccination should be viewed as one component of a comprehensive health management program. This includes regular health checks, appropriate nutrition, stress management and biosecurity. By integrating vaccination with other health measures, poultry farmers can ensure the overall well-being of their flocks and achieve optimal production outcomes.
In addition to vaccination, strict biosecurity measures should be implemented to protect the flock from Salmonella. This includes controlling access to the poultry houses, ensuring proper sanitation of equipment and facilities, and minimizing contact with wild birds and other animals that can carry Salmonella. Regular training for farm workers on biosecurity best practices can also help to reduce the risk of Salmonella introduction and spread.
About the author
Pascal Paulet: Poultry Corporate Marketing Director chez CEVA SANTE ANIMALE:
View his LinkedIn profile
Jaime Sarabia Fragoso: PhD. DVM. Poultry Global Veterinary Services Manager en CEVA SALUD ANIMAL
View his LinkedIn profile

